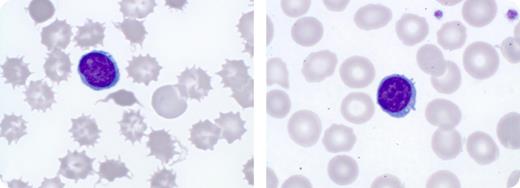
A 34-year-old patient with end-stage alcoholic liver cirrhosis became increasingly anemic and transfusion-dependent. On admission, he had a Coombs negative hemolytic anemia and a blood smear that showed marked poikilocytosis with numerous spiculated red blood cells (shown, left). / A diagnosis of spur cell anemia was made. Spur cell anemia is found in end-stage alcoholic liver disease. The morphologic changes of spur cells are caused by accumulation of excess membrane cholesterol, leading to an impaired deformability and consequently a reduced red cell survival. The prognosis of patients with spur cell anemia is poor, with a median survival of a few months. Liver transplantation represents the only potentially curative option. / The patient underwent liver transplantation but experienced primary graft failure with consecutive need for urgent retransplantation. Within 3 months after the second liver transplantation, spur cells had disappeared (shown, right) with a sustained improvement of the anemia and transfusion independence. Currently, 12 months after alcohol cessation and 6 months after transplantation, the patient is doing well with normal peripheral blood values.

A 34-year-old patient with end-stage alcoholic liver cirrhosis became increasingly anemic and transfusion-dependent. On admission, he had a Coombs negative hemolytic anemia and a blood smear that showed marked poikilocytosis with numerous spiculated red blood cells (shown, left).
A diagnosis of spur cell anemia was made. Spur cell anemia is found in end-stage alcoholic liver disease. The morphologic changes of spur cells are caused by accumulation of excess membrane cholesterol, leading to an impaired deformability and consequently a reduced red cell survival. The prognosis of patients with spur cell anemia is poor, with a median survival of a few months. Liver transplantation represents the only potentially curative option.
The patient underwent liver transplantation but experienced primary graft failure with consecutive need for urgent retransplantation. Within 3 months after the second liver transplantation, spur cells had disappeared (shown, right) with a sustained improvement of the anemia and transfusion independence. Currently, 12 months after alcohol cessation and 6 months after transplantation, the patient is doing well with normal peripheral blood values.
A 34-year-old patient with end-stage alcoholic liver cirrhosis became increasingly anemic and transfusion-dependent. On admission, he had a Coombs negative hemolytic anemia and a blood smear that showed marked poikilocytosis with numerous spiculated red blood cells (shown, left).
A diagnosis of spur cell anemia was made. Spur cell anemia is found in end-stage alcoholic liver disease. The morphologic changes of spur cells are caused by accumulation of excess membrane cholesterol, leading to an impaired deformability and consequently a reduced red cell survival. The prognosis of patients with spur cell anemia is poor, with a median survival of a few months. Liver transplantation represents the only potentially curative option.
The patient underwent liver transplantation but experienced primary graft failure with consecutive need for urgent retransplantation. Within 3 months after the second liver transplantation, spur cells had disappeared (shown, right) with a sustained improvement of the anemia and transfusion independence. Currently, 12 months after alcohol cessation and 6 months after transplantation, the patient is doing well with normal peripheral blood values.
Many Blood Work images are provided by the ASH IMAGE BANK, a reference and teaching tool that is continually updated with new atlas images and images of case studies. For more information or to contribute to the Image Bank, visit http://imagebank.hematology.org.